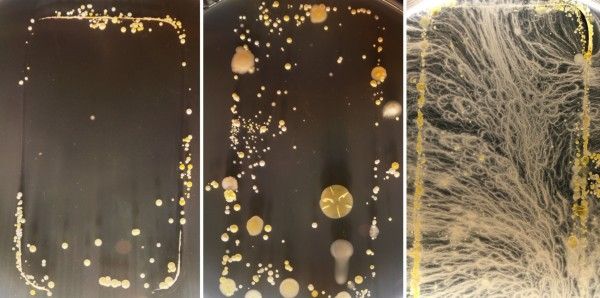

Vi abbiamo parlato già in un precedente articolo dei batteri che infestano i moderni smartphone e tablet. Un “pericolo” che, ovviamente, riguarda anche le tastiere dei computer, in ufficio e a casa. Un aspetto che occorre considerare visto che, seppur puliti, questi dispositivi sono in realtà degli oggetti sporchi e con i quali si viene a contatto quotidianamente. Ciò, di conseguenza, porta al proliferare di alcune colture batteriche che incidono pesantemente sulla trasmissione delle influenze di stagione.
Le influenze di stagione sono sempre in agguato e i virus si nascondono in ogni angolo dell’ufficio. A volte ci si ammala comunque ma ci sono precauzioni che si possono prendere. Mantenere pulite il più possibile le aree di lavoro e gli spazi comuni, per esempio, è già un primo passo per ridurre il rischio di trasmettersi l’influenza in ufficio.
Il servizio sanitario nazionale britannico, ad esempio, ricorda che alcuni virus possono vivere per settimane su superfici dure, come scrivanie e piani di lavoro della cucina ma, ancora più preoccupante, sulle tastiere dei computer.
L’azienda Viking ha deciso di fare un piccolo esperimento, permettendo ad alcune colture batteriche di crescere. Ciò mostra gli strani germi che ci circondano ogni giorno e che crescono indisturbati. Si è deciso così di passare un tampone su tutte le superfici e gli oggetti con cui le persone entrano in contatto, nelle aree comuni dell’ufficio e i risultati sono stati affascinanti e, allo stesso tempo, disgustosi.

Il metodo
Grazie all’aiuto e sotto la guida di alcuni tecnici di laboratorio di un college, gli addetti all’esperimento si sono procurati delle piastre di Petri riempite di agar. Questi ultimi non sono altro che piccoli piatti di plastica o vetro con coperchio, al cui interno è stato messo dell’agar – una gelatina nutriente – utilizzata come terreno di coltura per i microrganismi come i batteri. Inoltre, altri strumenti necessari sono stati i comuni Cotton fioc, le salviettine imbevute di alcol, del nastro adesivo, un’etichettatrice e del sapone antibatterico.
Si è poi proceduto a prendere i tamponi sugli oggetti con cui più probabilmente gli impiegati entrano in contatto quotidianamente. Gli oggetti e le superfici che si sono scelte di analizzare sono stati:
– Bollitore dell’acqua
– Mouse
– Fotocopiatrice
– Tastiera
– Scrivania
– Mouse pulito
– Maniglia della porta
– Cornetta telefonica
– Matita “masticata”
– Penna “masticata”
Dopo aver passato singolarmente sulle aree i cotton fioc sterilizzati, questi sono stati strisciati a zig-zag nelle piastre di Petri sulla superficie gelatinosa dell’agar. È stato necessario sterilizzare prima dell’uso i bastoncini di cotone con delle salviettine imbevute d’alcol, e aspettare che evaporasse. In questo modo, gli unici batteri raccolti sarebbero stati quelli presi dalla superficie del campione (e non i batteri già presenti). Infine, si è proceduto ad etichettare i piattini e a metterli in una scatola di plastica trasparente in un ambiente caldo per cinque giorni.
È importante lavorare con metodo e attenzione per evitare contaminazioni accidentali. Il coperchio di ogni piastra Petri è stato aperto solo il tempo necessario di strisciarvi il cotton fioc e poi è stato immediatamente chiuso, etichettato e immagazzinato. I ricercatori hanno anche lavato le mani dopo aver maneggiato ogni campione per evitare contaminazioni con i tamponi e qualsiasi contatto con la pelle.
I risultati
Dopo cinque giorni, si è appurato che le colture batteriche e i funghi si sono moltiplicati esponenzialmente. E il contenuto delle piastre evidenziavano la quantità e diversità di germi in agguato sulle superfici dell’ufficio. “Basandoci sui risultati ottenuti dai tamponi questi e su ciò che sappiamo degli ambienti dove sono stati prelevati i campioni, si può dire che, probabilmente, gli organismi presenti sono: muffe (colonie blu), stafilococchi (spesso provengono dalle mani e dalle mucose del naso) e enterobatteri (indicatori dell’igiene ambientale)”, spiega il microbiologo clinico, esperto in materia, che lavora presso un laboratorio di analisi governativo in Irlanda del Nord ed interpellato per il test. “La temperatura e la disponibilità di sostanze nutrienti sono fattori importanti che influenzano la proliferazione di batteri e muffe. Superfici calde e umide permettono uno sviluppo molto più rapido in poche ore.” E continua: “Alcuni microrganismi possono sopravvivere solo per poche ore su determinate superfici. Altri invece possono rimanerci per mesi, specie se alimentati e “salvaguardati” da altra sporcizia. I microorganismi proliferano nelle zone che non sono pulite e creano un ambiente protetto rilasciando delle sostanze che creano un biofilm.”
Mouse
Poiché i campioni presi sul mouse appena pulito hanno visto una crescita quasi nulla, ciò ha dimostrato ancora di più l’importanza di pulire regolarmente gli oggetti e le superfici di lavoro, soprattutto quando qualcuno nel vostro ufficio è malato.

Scrivania
Il campione preso dalla scrivania ha mostrato la più vasta gamma di batteri, funghi, ecc… Ciò è probabilmente dovuto a tutto ciò che appoggiamo sulla superficie giornalmente. La tendenza di molti dipendenti di mangiare sulla scrivania è probabilmente un fattore responsabile di alcuni dei microorganismi presenti all’interno di questa piastra di Petri.
Fotocopiatrice
La fotocopiatrice si è dimostrata molto più sporca di quanto sembrasse. Si è concluso che ciò è dovuto al fatto che è utilizzata da molte persone, ma anche che le sue superfici non vengono pulite con regolarità. E’ bene, quindi, disinfettarla regolarmente per prevenire la proliferazione di batteri. “La scrivania e la fotocopiatrice sembrano abbastanza sporchi; ciò è ovviamente dovuto al fatto che sono usati da molte persone.”

Bollitore dell’acqua
Il bollitore per l’acqua dell’ufficio ha mostrato una crescita interessante e unica, differente rispetto a quella degli altri campioni. Questo si deve anche al fatto che il tampone è stato preso su un’area solitamente molto più calda rispetto al resto dell’ufficio.
Maniglia della porta
La porta invece non è stata altrettanto sorprendente e la crescita di microrganismi è stata limitata in confronto agli altri campioni. Probabilmente ciò è dovuto al fatto che è pulita ogni giorno dagli addetti alle pulizie dell’ufficio. Però questo rende la crescita osservata ancora più rilevante, in quanto frutto di un solo giorno di esposizione e contatti, e dimostra quanto un oggetto possa essere un punto di contagio anche se quotidianamente pulito. “Il bollitore e la porta invece hanno pochi microrganismi, specie se paragonati alla scrivania e alla porta, e ciò è dovuto al fatto che sono costituiti da superfici non assorbenti e facili da pulire. Alcuni metalli hanno un effetto antimicrobico, e questo potrebbe essere il caso della maniglia della porta.”

Matita e Penna “masticate”
La matita e la penna “mangiate” sembrano essere il rifugio ideale per molti germi. In questo caso il problema è che, se qualcuno mastica una penna, crea un punto di contagio che poi è portato in giro; prestandola a un collega, lo si espone al rischio di essere attaccato da orde di germi e batteri che potrebbe farlo ammalare. Per di più se la penna è già contaminata, chi la mastica si porta direttamente la contaminazione in bocca. “La matita ha dato luogo a molte muffe e ciò è dovuto alla porosità del legno. Il mantenerla anche umida con la saliva ha contribuito a una maggiore crescita! Ci dovrebbero essere anche batteri orali, come difteroidi e streptococchi.”

Telefono e Tastiera
I campioni presi su telefono e tastiera sono stati sorprendenti per la relativa assenza di sviluppi. Questo può semplicemente derivare dal fatto che le superfici erano state pulite più recentemente di quanto si immaginasse. Tuttavia, la migliore ipotesi è che non si sia lasciato evaporare tutto l’alcol della sterilizzazione e, quindi, sono stati uccisi la maggior parte dei batteri prelevati con il tampone. Nonostante ciò le colonie presenti sono comunque vistosamente distinguibili. “Il telefono e la tastiera sono relativamente puliti. Questo è un po’ sorprendente ma, il fatto di avere superfici non porose, ha sicuramente aiutato a limitare la crescita di organismi.”

Tirando le somme dell’esperimento, si è scoperto che la maggior parte delle aree di un ufficio sono sporche e qualche zona richiede una pulizia più regolare. Vale la pena ricordare, tuttavia, che i microrganismi – come i batteri – prosperano ovunque e mantenere tutto costantemente sterile sarebbe utopico e inutile, vivendo a contatto, ogni giorno, con microrganismi simili a questi. Gran parte dei batteri rilevati erano comunque in quantità talmente limitata da non poter nuocere gravemente alla salute, ma si è pensato che fosse interessante condividere i risultati e ragionare insieme sulle aree dove i contagi possono aver luogo. “Le persone con tagli o che sono immunocompromessi hanno un rischio più alto di venire a contatto con i microrganismi presenti in ufficio o altrove. In generale, comunque, le infezioni sono rare, nonostante il gran numero di microrganismi che si possono trovare. Questo perché il nostro sistema immunitario è molto efficace a proteggerci. I maggiori rischi d’infezione in ufficio provengono dai virus respiratori, come la comune influenza o il raffreddore e da norovirus che possono causare vomito o diarrea. Tutte le superfici testate dimostrano il potenziale rischio del trasferimento di organismi infettivi per contatto mano a bocca”, dichiara ancora l’esperto. “La conclusione che si può trarre è semplice e non è una novità: lavate le mani con acqua calda e sapone e, in generale, mantenete il posto di lavoro pulito e curato giornalmente con dei detergenti.”

























